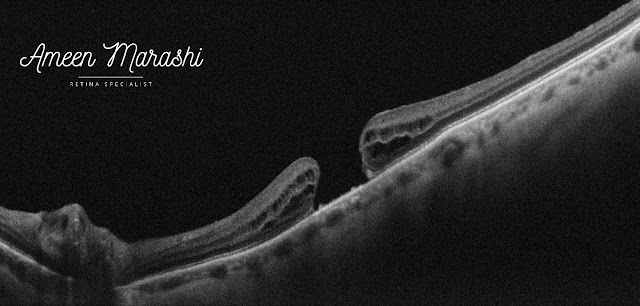

A 68 years old lady systematically free presented with symptoms of distorted vision three months ago on her left with BCVA counting fingers and BCVA in the right eye is 20/20.
Clinical examination of her left eye shows the anterior and posterior segment unremarkable. In contrast, in her right eye, the anterior segment exam is unremarkable. Her fundus exam shows myopic changes with completed posterior PVD abnormal foveal reflex.
Fundus image
Fundus colored photograph shows myopic changes of the posterior pole with macular hole formation and yellow deposits.
![]() |
| Fundus image showing full-thickness macular hole |
Optical coherence tomography
OCT scan shows an absence of operculum along with complete posterior vitreous detachment.
OCT features full-thickness foveal defect with increased thickness of surrounding tissue with the cystic formation and some RPE deposits the width of the hole is 732 microns while the height is 522 microns.
![]() |
| OCT cross-section showing stage four full-thickness macular hole |
The enface image in the level of Vitreous/ILM shows a central hole at the fovea with tissue defect
![]() |
| EnFace OCT in the level of Vitreous/ILM featuring macular hole |
Diagnosis: Macular Full-thickness hole stage 4
Management is pars plana vitrectomy with ILM peeling with a guarded prognosis.
Discussion
Vitreomacular traction (VMT) is the main pathological factor of a full-thickness macular hole. However, it can be combined with an epiretinal membrane, especially in stage three or four.
Full-thickness macular hole presented in 4 stages
Stage 1 features VMT with a defect in outer retinal layers; on clinical examination, the fundus looks like a yellow dot in the fovea center.
Stage 1b there would be VMT with a defect in the outer and inner retinal layers but not a full-thickness sparing the ILM, and clinically features a yellow circle at the center of the fovea.
Stage 2 would be a full-thickness macular hole (FTMH) usually less than 400 microns with an attached operculum with or without vitreous traction.
Stage 3, where there is FTMH with a detached operculum and can be 400 microns and more and features pseudo cystic changes along with tea table configuration of the surrounding tissue with attached posterior vitreous on the optic disc.
Stage 4, the PVD is complete where Weiss ring can be noticed in clinical examination, and the hole is always larger than 400 microns.
Management of macular hole can be ranged from observation in stage one, which can close spontaneously in 50% of cases. Stage 2 can respond to pharmacological or pneumo vitreolysis in cases with small holes with persistent vitreous attachment.
Stage 3 and 4 require Pars plana vitrectomy with ILM peeling. Some refractory cases may require inverted flap technique or autologous retinal transplant in cases of refractory macular holes in high myopic eyes and when the macular hole is larger than 1000μm.

Very nice information, This information will always help everyone for gaining knowledge. So please always share your important information. I am very thankful to you for providing essential information. yorktown eye doctor
ReplyDeleteYou have mentioned here great information here. I would like to say this is a well-informed article and also beneficial article for us. Keep sharing this kind of articles, Thank you.Pterygium Surgery Recovery
ReplyDelete